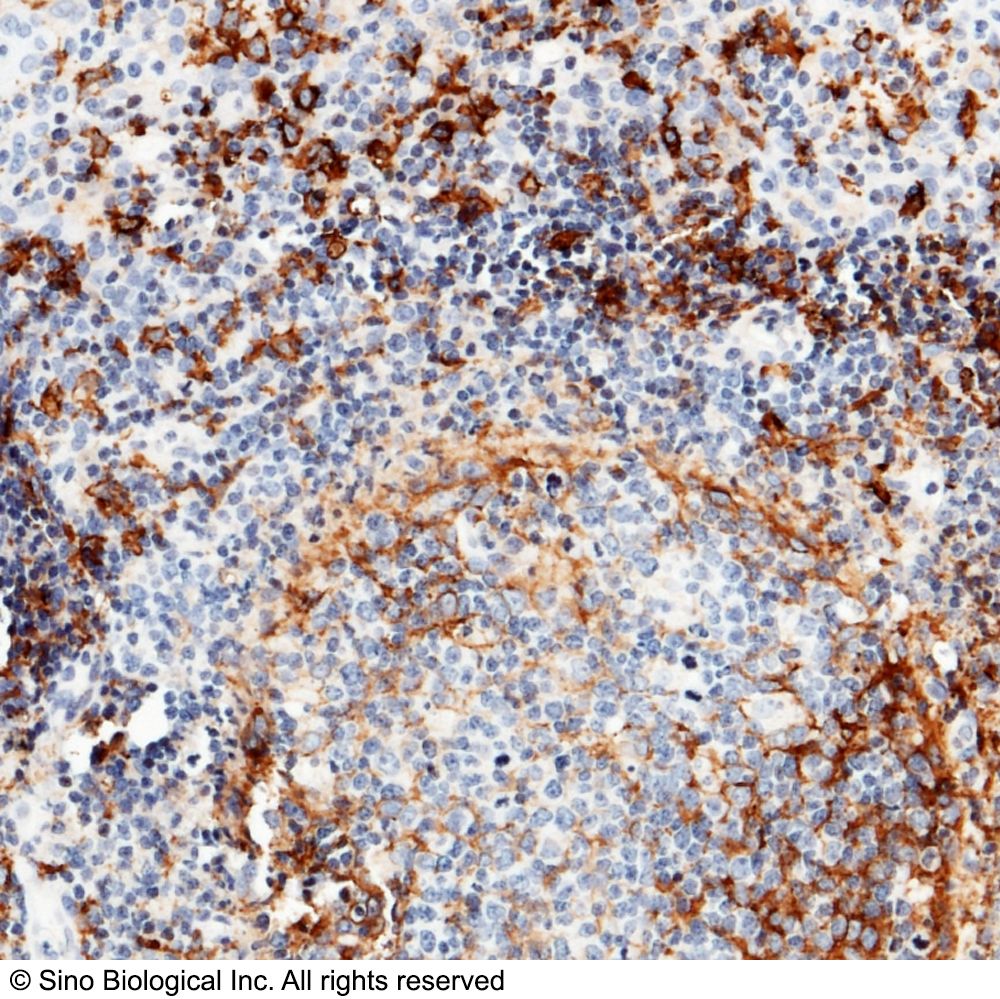
产品封面图

研选同类产品更多 >
万千商家帮你免费找货
0 人在求购买到急需产品
- 详细信息
- 用户评价
- 文献和实验
- 技术资料
- 免疫原:
Recombinant Human CD14 protein (Catalog#10073-H08H)
- 亚型:
Rabbit IgG
- 形态:
液体
- 保存条件:
在-20℃ to -80℃
- 克隆性:
MAb
- 适应物种:
兔
- 保质期:
12个月
- 抗原来源:
10073-H08H
- 目录编号:
10073-R001
- 级别:
免疫学试剂
- 库存:
99
- 供应商:
北京义翘神州科技股份有限公司
- 宿主:
Rabbit
- 应用范围:
IHC-P
- 浓度:
IHC-P: 1:100-1:500
- 靶点:
CD14
- 抗体英文名:
CD14 Antibody, Rabbit MAb
- 抗体名:
CD14 兔单抗
- 规格:
20 µL/100 µL
| 规格: | 20 µL | 产品价格: | ¥800.0 |
|---|---|---|---|
| 规格: | 100 µL | 产品价格: | ¥2299.0 |
CD14|CD14 antibody|CD14抗体|Anti-Human 兔单抗(产品说明)
抗体种属:Human
抗体靶点:CD14
抗体应用:IHC-P
抗原货号:10073-H08H
抗原描述:Recombinant Human CD14 protein (Catalog#10073-H08H)
抗体宿主:Rabbit
抗体Ig类型:Rabbit IgG
抗体纯化方法:Protein A
抗体制备:This antibody was obtained from a rabbit immunized with purified, recombinant Human CD14 (rh CD14; Catalog#10073-H08H; NP_000582.1; Met1-Met344).
抗体特异性:Human CD14
抗体保存:This antibody can be stored at 2℃-8℃ for one month without detectable loss of activity. Antibody products are stable for twelve months from date of receipt when stored at -20℃ to -80℃. Preservative-Free. Avoid repeated freeze-thaw cycles.
风险提示:丁香通仅作为第三方平台,为商家信息发布提供平台空间。用户咨询产品时请注意保护个人信息及财产安全,合理判断,谨慎选购商品,商家和用户对交易行为负责。对于医疗器械类产品,请先查证核实企业经营资质和医疗器械产品注册证情况。
用户评价
暂无用户评价
文献和实验1, Kuriakose J, et al. Patrolling monocytes promote the pathogenesis of early lupus-like glomerulonephritis.The Journal of clinical investigation, PubMed ID: 31033479
2, Wang B, et al. Microlocalization and clinical significance of stabilin-1+ macrophages in treatment-naïve patients with urothelial carcinoma of the bladder.World journal of urology, PubMed ID: 31302753
人可溶性CD14 ( sCD14 )ELISA 试剂盒 ( 用于血清、血浆、细胞培养上清液和其它生物体液内 ) 原理 本实验采用双抗体夹心 ABC-ELISA 法。用抗人 sCD14 单抗包被于酶标板上,标准品和样品中的 sCD14与单抗结合,加入生物素化的抗人 sCD14 ,形成免疫复合物连接在板上,辣根过氧化物酶标记的 Streptavidin 与生物素结合,加入底物工作液显蓝色,最后加终止
大鼠可溶性CD14分子(sCD14)ELISA试剂盒 说明书
上海西唐生物科技有限公司 021-55229872, 65333639 www.westang.com 大鼠可溶性 CD14 分子 (sCD14)ELISA 试剂盒 ( 用于血清、血浆、细胞培养上清液和生物体液内 ) 原理 本实验采用双抗体夹心 ABC-ELISA 法。用抗大鼠 sCD14 单抗包被于酶标板上,标准品和样品中的 sCD14 与单抗结合,加入生物素化的抗大鼠 sCD14 ,形成免疫
D 的抗体,选择抗体时可优先挑选经过验证的,如有组织染色的结果更佳,像是 GeneTex 的兔单抗 GTX635362。GTX635362 RAS(G12D 突变体)抗体通过使用多种细胞及正常与癌组织对照进行正交策略验证;在人胰腺癌细胞系和 PDAC 小鼠模型的 RAS G12D 突变蛋白表现出高度的敏感性和特异性。左图为印迹(WB)和右图为免疫组化(IHC-P)。5. 蛋白过表达利用在细胞中过表达目标蛋白,并收取细胞裂解液后进行 WB 分析,理论上蛋白量增多,抗体辨识后的信号也会增强,因此可确认抗体
技术资料暂无技术资料 索取技术资料